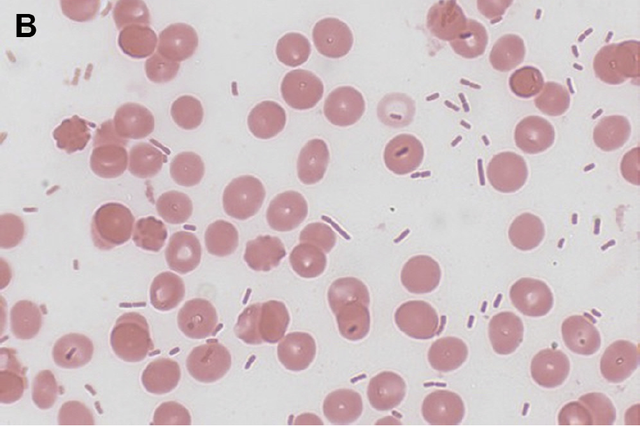

当孩子出现腹泻的情况的时候,要怎么治疗孩子比较好,孩子出现腹泻怎么办好呢,小编就来说说针对孩子的腹泻的治疗方案吧。
哪些才是靠谱的治疗方案
对于急性腹泻来说,并没有止泻特效药,最关键的是预防脱水和电解质紊乱,治疗措施主要包括应用口服补液盐、补充锌剂等。
口服补液盐
口服补液盐是宝宝急性腹泻最主要、最关键的措施,最常用的是口服补液盐III(ORS III),可以快速补充水分及电解质,并且能减少静脉补液率,缩短腹泻病程。
为预防脱水,宝宝腹泻开始时就需要口服一定量的冲兑好的口服补液盐III,可以一次性冲一整包,按比例配好后,不分餐前餐后,分多次慢慢喝下去,直至腹泻停止。

锌
孩子反复腹泻时,从肠道丢失微量元素多,其中以锌元素丢失明显。
目前指南推荐6个月及以下宝宝腹泻时每天补锌元素10mg,6个月以上宝宝腹泻时每天补充锌元素20mg。
最常用的锌补充剂包括葡萄糖酸锌颗粒或片剂,建议餐后吃,持续吃10—14天,即使后续孩子不拉了也坚持吃足时间。
肠粘膜保护剂
肠粘膜保护剂主要是对症支持治疗,大家比较熟悉的蒙脱石散为黏土类的肠粘膜保护剂。
但是,蒙脱石散效果有限,只是会让大便看起来粘稠一些,并不能缩短腹泻病程。
如果孩子愿意吃,可以吃,不愿意吃,也不勉强。蒙脱石散需要空腹吃,且吃药后至少半小时内不能喝水、吃奶或吃其他药物。
什么情况下需要及时就医
孩子腹泻一般有自限性,家长不用太担心,但当孩子有以下症状时,可能提示严重脱水或电解质紊乱,建议带宝宝去医院治疗。
呕吐频繁、不愿意进食及喝口服补液盐
精神状态不好、嗜睡或是烦躁不安难以安抚、面色难看
反复高热不退、有抽搐
腹胀
明显血便
眼窝凹陷,哭的时候没有眼泪,口唇明显干燥,尿量少,手脚冰凉
有严重基础疾病,营养不良
